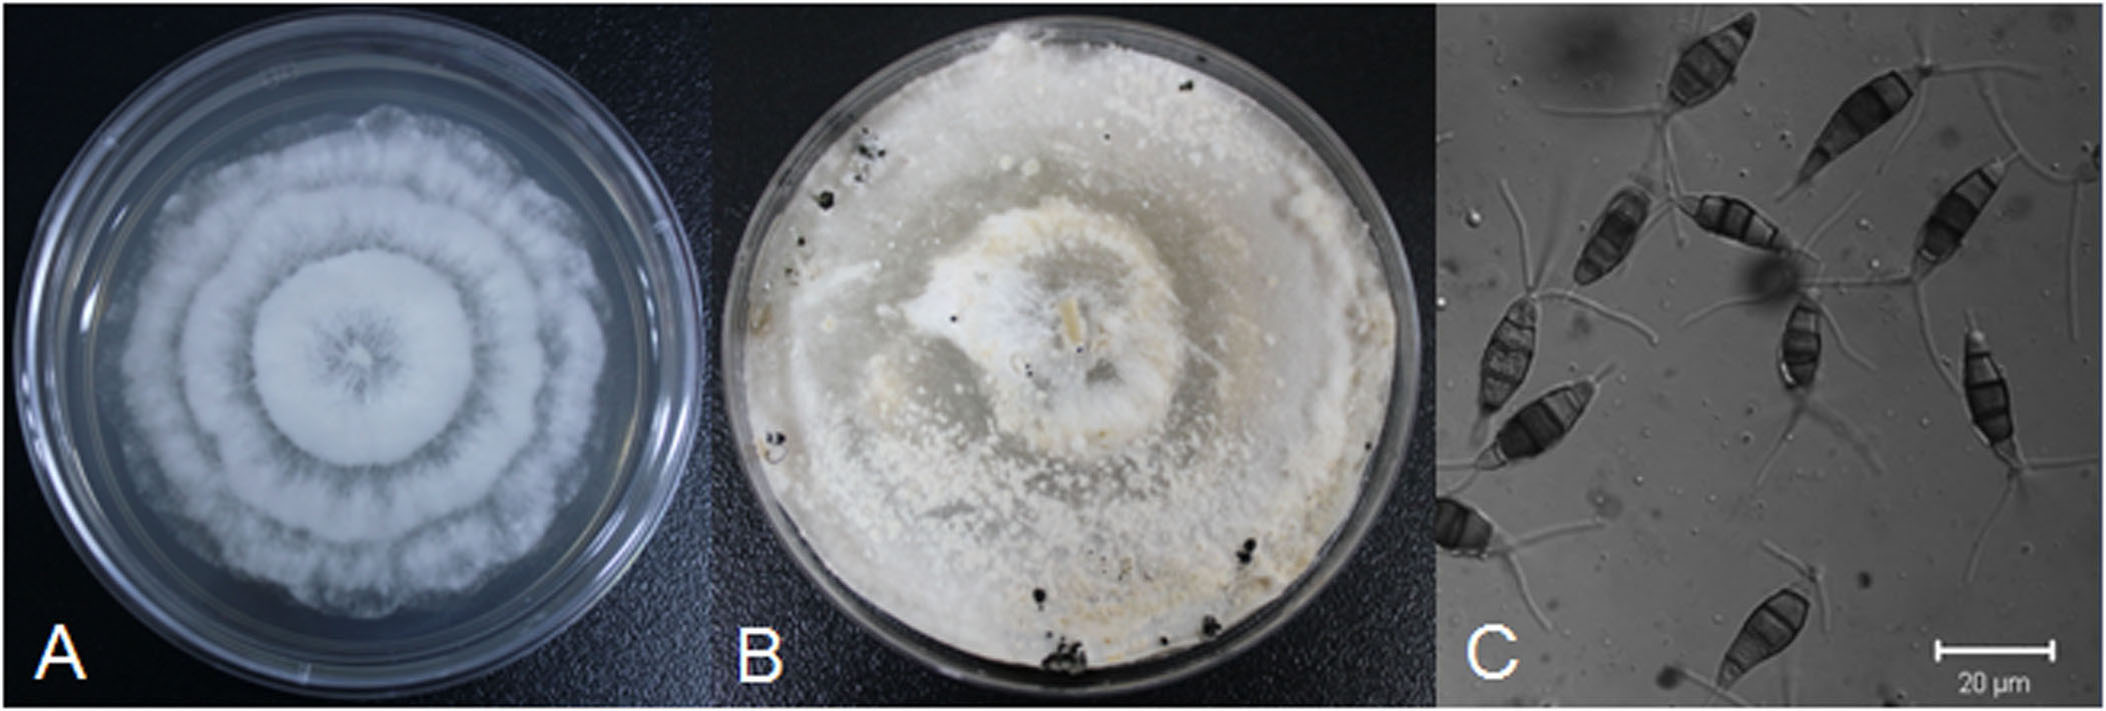

猕猴桃(Actinidia spp.)隶属猕猴桃科(Actinidiaceae)猕猴桃属(ActinidiaLindl.),具有很高的营养及经济价值。我国是世界猕猴桃起源和分布中心,拥有丰富的猕猴桃种质资源。2015年,中国的猕猴桃年产量达到250万吨,总栽培面积超过25万公顷,连续10年超越新西兰及意大利成为世界猕猴桃栽培面积和产量最大的国家。然而,随着近年来栽培面积的迅速扩大,猕猴桃细菌性及真菌性病害的发生情况日益突出,严重威胁了猕猴桃产业的健康发展。
猕猴桃真菌性软腐病是发生在果实贮藏期的一种常见病害。发病初期果实外表无明显症状;随着病情发展,发病部位表皮开始变软,微微凹陷,剥开凹陷部的表皮,可发现病部中心果肉呈乳白色,周围果肉呈黄绿色透明状。纵剖病果可以看到病变组织呈圆锥状向果肉深部扩展,6-10天左右病斑扩散至果实中间至整个果实完全腐烂。正常条件下,猕猴桃可以在适宜的低温冷库中保存4-8个月,软腐病的发生会加速猕猴桃的腐烂,导致在贮藏、转运、销售期间产生严重的经济损失。
猕猴桃种质资源与育种学科组李黎助理研究员在钟彩虹研究员的指导下,于2014-2015年对中国猕猴桃果实软腐病的发生进行了大规模地调查,发现该病已成为中国猕猴桃产区最重要的真菌病害,且有逐年加重的趋势,在四川、陕西、河南、湖北及湖南等猕猴桃主产区的发病率高达20%-50%。同时,对收集自河南、湖北、重庆、江西、贵州、陕西、四川、浙江、福建、安徽及湖南等地区的猕猴桃软腐病样本进行了病原菌分离。运用生物学特性观察、致病性测定及ITS分子鉴定等方法,发现引起中国猕猴桃软腐病的主要病原菌是拟茎点霉菌(Phomopsis sp.)、葡萄座腔菌(Botryosphaeriadothidea)、链格孢菌(Alternariaalternata)、盘多毛孢菌(Pestalotiopsissp.)。不同地区的病原菌存在明显差异,如四川、贵州、福建、浙江及湖南的拟茎点霉菌检出率较高,安徽及上海的葡萄座腔菌检出率较高。其中Pestalotiopsismicrospora,Diaporthelithocarpus为首次被鉴定为中国猕猴桃软腐病的病原菌。该研究首次对中国猕猴桃软腐病的病原菌进行了系统分析,揭示了中国猕猴桃软腐病菌的分布规律,为后期的抗性机理研究、抗病品种选育及防治等工作奠定了基础。
本研究得到了中国科学院科技服务网络计划研究项目(KFJ-EW-STS-076),农业部作物种资质源保护与利用项目(2015NWB027)支持。研究成果已分别发表在Plant Disease杂志第10期,第11期上。

Diaporthelithocarpus 菌株的生物学特征及导致的猕猴桃软腐病症状
Pestalotiopsismicrospora 菌株的生物学特征


